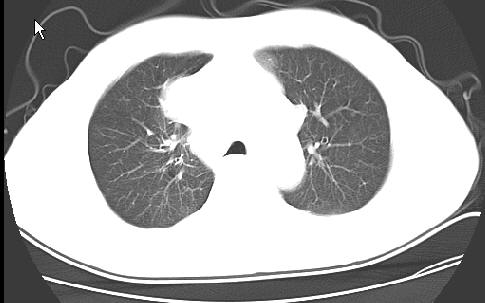

以下是引用草之原在2009-5-2 19:29:00的发言:[br]1.考虑右侧中心型肺ca纵膈淋巴结转移,双侧胸腔积液及右侧叶间裂积液,心包积液。[br]2.两肺上叶病灶,纵膈窗显示部分病灶硬化,考虑:结核。[br][br] [br]
以下是引用草之原在2009-5-2 19:29:00的发言:[br]1.考虑右侧中心型肺ca纵膈淋巴结转移,双侧胸腔积液及右侧叶间裂积液,心包积液。[br]2.两肺上叶病灶,纵膈窗显示部分病灶硬化,考虑:结核。[br][br] [br]
以下是引用ct诊断高手在2009-5-2 19:08:00的发言:[br]我考虑右侧中央型肺癌 伴右肺节段性不张,两肺及纵隔淋巴结转移,右侧胸腔积液。
以下是引用zjzjr在2009-5-2 20:16:00的发言:[br]肺结核,转移瘤.纵隔淋巴结转移或淋巴瘤,右侧包裹性积液、斜裂积液。心包积液。
以下是引用zjzjr在2009-5-2 20:16:00的发言:[br]肺结核,转移瘤.纵隔淋巴结转移或淋巴瘤,右侧包裹性积液、斜裂积液。心包积液。
| 欢迎光临 医影在线 (http://bbs.radida.com/bbs/) | Powered by Discuz! X3.2 |